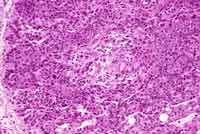

ANSWER
– Lymphangioma– Lymphangiectasia
– Lymphangiomatosis
– Lymphatic Dysplasias
– Idiopathic Effusion
– Congenital Chylothorax
– Lymphatic abnormalities & inherited disorders -- e.g. Gorham's disease
FURTHER HISTORY
The diagnosis was established via an open lung biopsy.BELOW
are the PATHOLOGY SLIDES

CLICK on ANY SLIDE to see an ENLARGEMENT.
You
will notice the following features on the slides:
1) Marked vascular pulmonary thrombosis: arteries with focally marked
medial and intimal hyperplasia consistent with hypertensive arteriopathy
2) Lymphangiectasia: Focally marked dilatation of pleural and interlobular
septal lymphatic channels with edematous expansion of the interlobular
septa
3) Pulmonary venous dilation: veins are dysmorphic
4) Patchy absence of airways: either bronchiolitis obliterans or small
airway hypoplasia
5) Patchy acute inflammatory cell infiltrate within the interstitium
Lymphangiectasia
(11)
Virchow first described lymphangiectasia in 1856.
It is the differential diagnosis for pulmonary cystic lesions, bilateral
obstructive emphysema, and chronic asthma / pneumonia
Pathology:
Pathologically, the lungs appear heavy and non-compliant. The visceral
pleura have a network of dilated lymphatics that weep lymph when sectioned.
Interlobular septa are widened and thickened. Additionally, lymphatic
spaces are dilated and occasionally cystic. Small amount of collagen,
smooth muscle may be found in vessel walls.
Three
Diagnostic Classification Groups:
There are three diagnostic groups to consider within lymphangiectasia:
Primary Pulmonary Involvement
Secondary/ acquired PL from either Venous obstruction (eg intravascular
thrombus) Cardiac morphological abnormalities
Generalized Lymphangiectasia: These patients usually have a less
severe form of disease with mild G.I symptoms. Patient with generalized
lymphangiectasia can have associated hypoproteinemia, edema and lymphopenia.
![]() Next page /
Archives / Contact
us
Next page /
Archives / Contact
us
